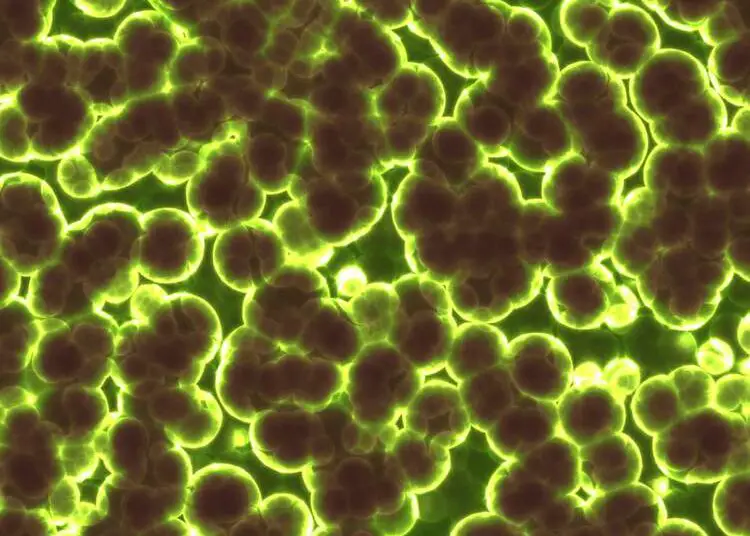

Une équipe de chercheurs australiens a réalisé une percée scientifique majeure en découvrant une enzyme capable de convertir l’air en énergie. Cette trouvaille fascinante révèle que cette enzyme utilise les infimes quantités d’hydrogène présentes dans l’atmosphère pour générer un courant électrique. Cette avancée ouvre la voie à la création de dispositifs capables de produire de l’énergie littéralement à partir de l’air ambiant.
Le mystère de la survie bactérienne enfin percé
L’équipe de recherche, dirigée par le Dr Rhys Grinter, la doctorante Ashleigh Kropp et le professeur Chris Greening de l’Université Monash à Melbourne, a isolé et analysé une enzyme consommatrice d’hydrogène issue d’une bactérie de sol très commune, Mycobacterium smegmatis.
Des travaux récents menés par cette même équipe avaient déjà démontré que de nombreuses bactéries utilisent l’hydrogène atmosphérique comme source d’énergie pour survivre dans des environnements extrêmement pauvres en nutriments. Le professeur Greening explique que les scientifiques savaient depuis un certain temps que les bactéries pouvaient exploiter les traces d’hydrogène dans l’air pour croître et survivre dans des lieux inhospitaliers, tels que les sols gelés de l’Antarctique, les cratères volcaniques ou les profondeurs océaniques. Cependant, le mécanisme exact permettant cet exploit demeurait un mystère jusqu’à cette découverte.
Huc : une enzyme d’une efficacité redoutable
Dans leurs travaux publiés par la prestigieuse revue Nature, les chercheurs expliquent comment ils ont extrait l’enzyme responsable de ce processus. Baptisée Huc, elle possède la capacité unique de transformer le gaz hydrogène en un courant électrique. Le Dr Grinter souligne l’efficacité extraordinaire de cette molécule : contrairement à toutes les autres enzymes et catalyseurs chimiques connus, elle parvient à consommer de l’hydrogène même lorsque celui-ci se trouve à des niveaux bien inférieurs à ceux de l’atmosphère, fonctionnant avec seulement 0,00005 % de l’air que nous respirons.
Pour percer à jour le fonctionnement complexe de cette oxydation de l’hydrogène atmosphérique, les scientifiques ont eu recours à des méthodes de pointe. Ils ont utilisé la microscopie électronique à transmission cryogénique pour déterminer avec précision sa structure atomique et ses voies électriques, repoussant ainsi les limites de cette technologie pour obtenir la structure enzymatique la plus détaillée à ce jour. Des techniques d’électrochimie ont également permis de prouver que l’enzyme une fois purifiée crée de l’électricité à des concentrations d’hydrogène minuscules.
Une véritable « batterie naturelle »
Les expériences en laboratoire menées par Ashleigh Kropp ont révélé qu’il est possible de stocker l’enzyme Huc purifiée sur de très longues périodes. Sa stabilité est impressionnante : qu’elle soit congelée ou chauffée jusqu’à 80 degrés Celsius, elle conserve intacte sa capacité à générer de l’énergie. Cette résistance exceptionnelle reflète le rôle crucial de l’enzyme dans la survie des bactéries au sein des environnements les plus hostiles de notre planète.
Fonctionnant comme une batterie naturelle, Huc produit un courant électrique continu à partir de l’air ou d’un ajout d’hydrogène. Bien que ces recherches n’en soient qu’à leurs balbutiements, cette découverte présente un potentiel considérable pour le développement de petits appareils fonctionnant à l’air, offrant ainsi une alternative novatrice et prometteuse aux dispositifs alimentés par l’énergie solaire.
Les bactéries produisant des enzymes telles que Huc sont très courantes et peuvent être cultivées en grandes quantités, garantissant ainsi une source durable et accessible. L’objectif principal des futurs travaux consistera à augmenter la production de Huc à grande échelle. Pour approfondir les détails techniques de cette recherche, il est possible de consulter la publication originale via son DOI: 10.1038/s41586-023-05781-7 ou de lire l’article complet directement sur le site de la publication.
Source : phys.org